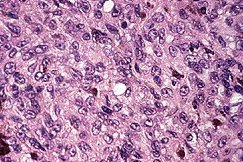

Choroidal melanoma with subretinal fluid
(the pink area around the dome-shaped lesion) |
A bisected globe showing an amelanotic mushroom-shaped
choroidal melanoma. |
Choroidal melanoma is a common topic in the pathology viva.
The specimen given can either be a slide or a bisected eye.
a
A section of an enucleated eye showing a
choroidal melanoma that has broken through
the Bruch's membrane into the vitreal cavity
giving rise to a "collar-stud" appearance. |
A histological slide showing a
mushroom-shaped choroidal
melanoma with retinal detachment.
. |
In both the slide and the bisected eye, comment on:
A large choroidal melanoma causing retinal detachment.
The red line represents the area of contract between the melanoma and the
sclera. |
A slide showing extension of the melanoma into the vortex
vein (V).
(note the melanoma in the lumen M) |
In the slide, the examiner will expect you to discuss the cell
type(s) present which again is of prognostic importance. The Callender
classification is the most commonly used classification and divide the
cell types into three.
 |
.
Spindle-A cells contain slender nuclei with delicate chromatin,
ill-defined or absent nucleoli, and no mitotic activity. The
cells resemble a choroidal naevus.
.
|
 |
Spindle-B cells contain plump
nuclei with small but prominent nucleoli and coarse chromatin. Mitotic
figures are common. |
|
Epitheloid cells are so-called
because they resemble epithelium cells with their eosinophilic (pink)
cytoplasms and oval-shaped nuclei. The cell sizes are variable . They are
also larger and pleomorphic compared with the spindle cells. The
nuclei may be multinucleated. Chromatin shows coarse clumping.
Mitotic figures are abundant. The cells have no cohesiveness. |
The histology sometimes reveals a mixture of cells usually a mix of
spindle and epitheloid cells. This is called the mixed type tumour.
Common viva questions:
-
What factors determine the prognosis of choroidal melanoma?
-
What are the cell types of choroidal melanoma?
-
What are the treatment options for choroidal melanoma?
|